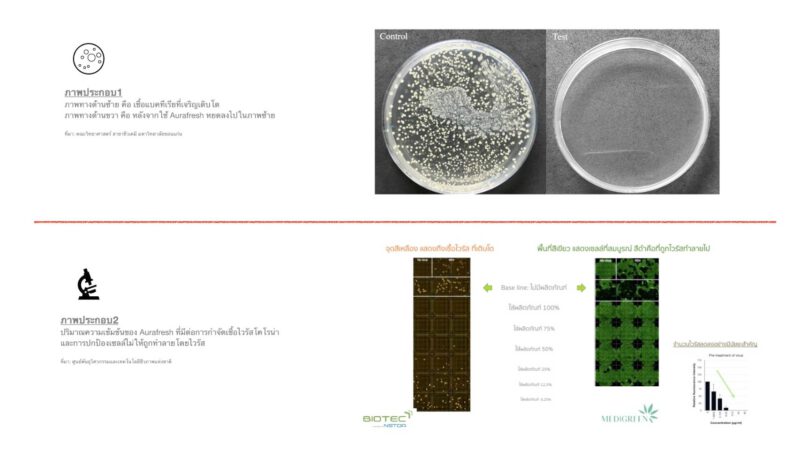

นวัตกรรมตำรับสมุนไพร สกัดไวรัสในปาก-คอเข้าสู่ร่างกาย

ช่วงการระบาดของโรคโควิด-19 ทุกคนคงต้องเตรียมพร้อมการ์ดไม่ให้ตก ทั้งหน้ากากอนามัย เจลอัลกอฮอล์ ตุนสมุนไพรฟ้าทะลายโจรและสมุนไพรต่างๆไว้เพื่อป้องกันการติดเชื้อในขณะที่รายงานตัวเลขผู้ติดเชื้อรายวันยังอยู่ในระดับสูง

อีกทางเลือกหนึ่งสำหรับทุกคน ได้แก่ “AuraFresh” นวัตกรรมตำรับสมุนไพรที่มีสารสกัดสมุนไพรออกฤทธิ์โดยตรงต่อไวรัสและผ่านการทดสอบในการยับยั้งโคโรน่าไวรัสเพียงหยดน้ำยาลงคอโดยตรง โดยออกแบบในรูปหลอดขนาดเล็กพกพาสะดวก สามารถใช้ได้ตามที่ต้องการ ไม่ว่าจะไปชอปปิ้งของเข้าบ้าน ไปประชุม ไปเจอลูกค้า ใช้บริการรถสาธารณะ หรืออื่นๆ ที่คิดว่ามีความเสี่ยง
“AuraFresh” พัฒนาจากแนวคิดที่ทีมวิจัยต้องการลดปริมาณไวรัสให้อยู่ในระดับที่ต่ำกว่าปริมาณที่ก่อให้เกิดโรค โดยใช้สารออกฤทธิ์จากธรรมชาติ
ซึ่งเชื้อโควิด 19 ใช้เวลา 3-5 วัน ในการเพาะขยายจำนวนในช่องปากและคอเพื่อให้มีปริมาณมากพอก่อนโจมตีร่างกาย โดยเฉพาะปอด…

**ข้อมูลเชิงลึกคือ
*การฟักตัวของโควิด 19 มีมากใน ช่องปาก และ คอ เป็นที่เชื้อไวรัสโคโรน่าชอบไปฟักตัว (incubation) เป็นที่แรก เพราะมีสภาพเหมาะสมกับการแบ่งเซลล์ เพื่อเพิ่มจำนวนไวรัส และเมื่อเชื้อไวรัสมีจำนวนมากพอ พวกมันก็พร้อมจะเคลื่อนที่ลงไปที่ปอด
*“หน้ากากแค่ทางผ่าน แต่ช่องปากคือรังเพาะเชื้อ ทำลายรัง = แก้ปัญหา”
สนนราคาเพียง350 บาท
สนใจผลิตภัณฑ์ ติดต่อได้ที่ Line :sirirat หรือโทร: 06-1754-6169
สแกนติดต่อผ่านคิวอาร์โค้ดที่
